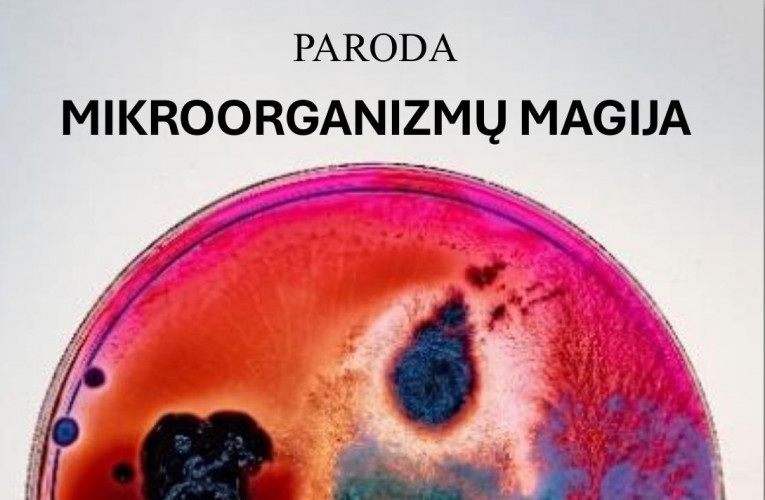
PARODOS PLAKATAS (1).jpg

Liepos 03 d.
Nacionaliniame saugomų teritorijų lankytojų centre liepos 3 d. 15 val. atsidarys įdomi paroda apie mikroorganizmus.
Parodos organizatorius - UAB GVT LT, kuri yra UAB „TOKSIKA“ dukterinė įmonė. Jos veikla yra pavojingų atliekų, užterštų naftos produktais, tvarkymas, naudojant draugiškus aplinkai biologinius valymo metodus. Tuos metodus pasitelkus, valymo metu išvengiama šalutinių kenksmingų produktų, o tai leidžia užtikrinti žemės resursų – grunto, vandens – atstatymą ir tokiu būdu sudaro galimybes mažinti neigiamą teršalų poveikį aplinkai. Per metus įmonė sutvarko apie 20 tūkst. tonų atliekų savo pavojingų atliekų tvarkymo kompleksuose, mažindama neigiamą teršalų poveikį aplinkai. Specifinė įmonės patirtis ir koncentravimasis į naftos produktais užteršto grunto valymo procesą leido sukurti naujų preparatų, mikroorganizmų kombinacijų.
Parodos nuotraukų autorius - fotomenininkas Paulius Makauskas, Vilniaus dailės akademijoje baigęs audiovizualinių menų studijas. 2020 m. menininkas tapo vieno iš prestižiškiausių fotografijos konkursų pasaulyje „International Photography Awards“ nugalėtoju.
Jis naudodamasis, bičiulio ir kolegos, fotografijos meistro Petro Saulėno sukonstruota specialia konstrukcija su mikroskopu fotografavimui, studijoje praleido kelias dienas įamžindamas plika akimi nematomus mikroorganizmus. Pasitelkęs šviesos magiją ir panaudodamas skirtingus spalvų efektus, fotomenininkas Paulius Makauskas pateikė spalvingus, kvapą gniaužiančius meno kūrinius – mikroorganizmų vaizdus.
Fotomenininko Pauliaus Makausko mintys: „Prieš pradėdamas šį projektą, net neįsivaizdavau, kad nafta užteršti dirvožemiai gali būti valomi mikroorganizmais. Tiksliau – žmogui bendradarbiaujant su mikroorganizmais yra atliekamas toks svarbus darbas. Labai sudomino toks kelias. Manau, tai labai stiprus simbolis bei nuoroda į tai, kaip turėtume matyti savo ateitį – lygiavertį tarprūšinį būvį. O galbūt kaip vienintelį būdą išgyventi. Išsaugoti ekosistemas su visais jos dalyviais, reiškia išsaugoti mus pačius.
Mokslininkai (dr. Algimantas Paškevičius, dr. Jurgita Švedienė ir doktorantas Jonas Žvirgždas) iš Gamtos tyrimų centro (GTC) Biodestruktorių tyrimo laboratorijos išaugino mikroorganizmus Petri lėkštelėse. Ten gyveno mielės, bakterijos, grybai. Gavome ir tuščių lėkštelių – pamokyti ant jų uždėjome užteršto grunto gabaliukus. Mūsų nuostabai, tarsi iš niekur, pradėjo augti įvairiausių spalvų ir formų besikeičiantys raštai. Tai priminė pačią gyvybės esmę – nežinia kaip atsiradusią, bet kuriančią stebuklus.